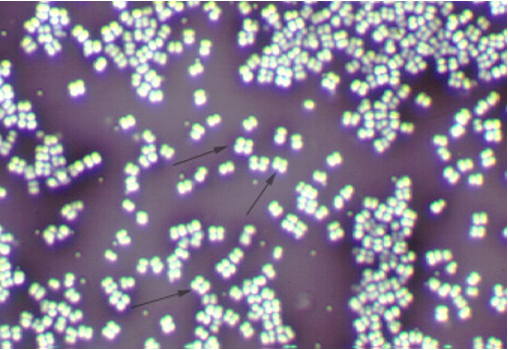

Microbiology Lab Exam Review- all quizzes
1/55
There's no tags or description
Looks like no tags are added yet.
Name | Mastery | Learn | Test | Matching | Spaced |
|---|
No study sessions yet.
56 Terms
To prepare and maintain a relatively sterile work area, you use
Aseptic technique, 70% alcohol sprayed on the bench, and a lighted Bunsen burner
what is the first thing you should consider doing if someone in the lab catches on fire?
fat them out as fast as you can
no open toe or open heel shoes are worn in the lab because..
broken glass or chemical spills may get into this kind of shoe
what may you pour down the sink
only things the instructor says
what is the first thing you do should someone at your bench spills or breaks something
stop moving until the instructor makes sure there is no glass that will cut you
biggest risk of injury for this lab
fire
in order to properly dispose of a contaminated substance in the lab you must
place it in biohazard container
The term Sepsis refers to
the presence of growing microorganisms
To sterilize living tissue, you must use
You can't sterilize living tissue
Non-living surfaces are called
Fomites
Microbicides are used on ______ while Microbistatics are used on ______
Fomites / Living tissue
An infection by a microbe while a person is in the hospital is classified as
A nosocomial or clinically acquired infection
Why must you wait for your inoculating loop to cool before using it
The specimen may aerosolize and be ejected into the air for you to breathe or absorb through your eyes
If Streptococcus pyogenes is normal microbiota of the throat, why don't you have strep throat
Microbial competition
What device do you use to transfer a microorganism sample
An inoculating loop
If you cannot sterilize your hands by washing them, why bother
You remove some organisms and inhibit the remainder, making your hands aseptic
Proteins are polymers of
Amino acids
Proteins can be
Structural, enzymatic, and used as a supply of amino acids to build other proteins
How many types of amino acids are used by living organisms
20
The covalent bonds that join amino acids are called
Peptide bonds
Which level of protein organization consists exclusively of hydrogen bonds
Secondary structure
What type of R-group interactions are possible in a protein
Covalent, ionic, and hydrogen bonding
The process whereby a protein acquires its functional shape is called
Folding
What determines the sequence of amino acids in a polypeptide
The sequence of nucleotides in an RNA molecule
Where in a cell are proteins synthesized
In the ribosome
A cell can change a protein's shape and function by
Attaching a charged particle such as phosphorus
Microorganism that grows best at pH 4
Acidophile
Microorganism that grows best at room temperature
Mesophile
Microorganism that grows best at high salt concentrations
Halophile
Microorganisms that require oxygen to make ATP are called
Aerobes
Atmospheric oxygen can form destructive radicals called
Superoxides
Amorphous bacteria in a hypotonic environment will
Lyse
Most potential pathogens grow at the same temperature as humans
True
Device to cultivate anaerobic bacteria in the lab
Candle jar, thioglycolate broth tube, or agar deep
Anaerobes use oxygen for
They don't use it; oxygen is poisonous to them
To survive oxygen presence, microbes must make
Superoxide dismutase and catalase
what type of staining procedure in the picture
Negative stain
Cell morphology in the picture
Cocci
Form of growth for this specimen
Strepto
An acidic stain provides internal structure info
False

Does this organism have a capsule (Simple Stain)
The Simple Stain does not provide that kind of information
Basic stains will stain external structures
True
Negative and Simple stains are differential
False
Acidic stains stain the ______ while basic stains stain the ______
Background / inside of cells
Heat fixing a slide
Kills the cells, sticks cells to the slide, and is necessary for basic stains
Amorphous bacteria have no peptidoglycan cell wall
True

Type of staining procedure in the picture
Gram stain
Gram Variable bacteria are in fact
Gram positive
Acid Fast bacteria belong to what genus
Mycobacteria
Differential stains typically require a counterstaining step
True

Which cells are acid fast
The bacilli-form cells
Basic stains will stain external structures
True
Negative and Simple stains are differential
False
Acid Fast bacteria have
A mycolic acid layer
Mycobacteria tuberculosis
None of the above (not fast-growing, no spores, not gram-negative)

Which cells are Gram positive (in Gram stain)
The staphylococci